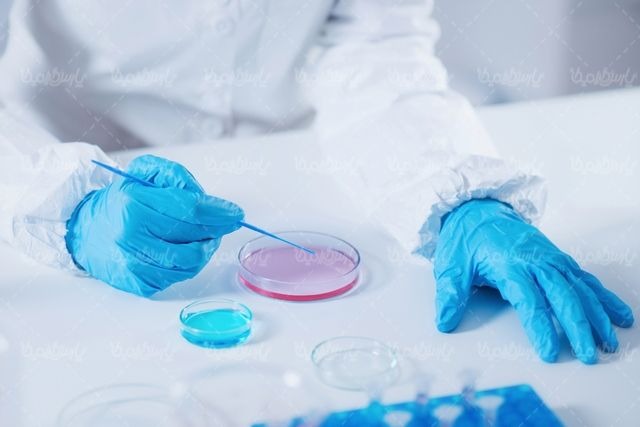
Pharmaceutical Analysis

Food Industries
Adhering to standards in hygiene, pharmaceutical, and food products is essential to ensure their quality and safety for consumers. These standards include a wide range of tests that challenge and evaluate all properties and characteristics of food, pharmaceutical, cosmetic, and hygiene products.
Kimia Hayat Arya is recognized as one of the most reputable and scientifically advanced laboratories affiliated with the Food and Drug Administration, the Medical Equipment and Supplies Directorate, the National Standards Organization, and the Strategic Technology Laboratory Network. The company offers a broad range of services including:
- Biocompatibility testing
- Microbiological analysis
- Cleanroom validation
- Molecular and cellular testing
- Animal studies
- Mechanical testing
These services are tailored for a variety of pharmaceutical products and medical devices.
Each year, numerous pharmaceutical and medical device companies send their products to Kimia Hayat Arya Laboratory for quality evaluation—to ensure product safety, functionality, and compliance with required standards.
We are proud to have established the largest biocompatibility laboratory at the National Institute of Genetic Engineering, equipped with state-of-the-art technology and staffed by a team of highly professional experts. Our goal is to deliver the highest quality testing services and support our clients in bringing safe and reliable products to the market.
Kimia Hayat Arya operates under the supervision and approval of the Food and Drug Administration. The company is responsible for conducting quality control tests on food, pharmaceutical, and hygiene products. These tests help verify the safety and quality of products, ensuring their compliance with the necessary national and international standards.
As an officially recognized and trusted institution, the test results provided by Kimia Hayat Arya are accepted by the Food and Drug Administration at all stages of the regulatory process, including licensing and certification.
The laboratory functions under the supervision of the General Department of Reference Laboratories for Food, Drug, and Medical Devices, and holds an official Partner Laboratory License from the FDA.